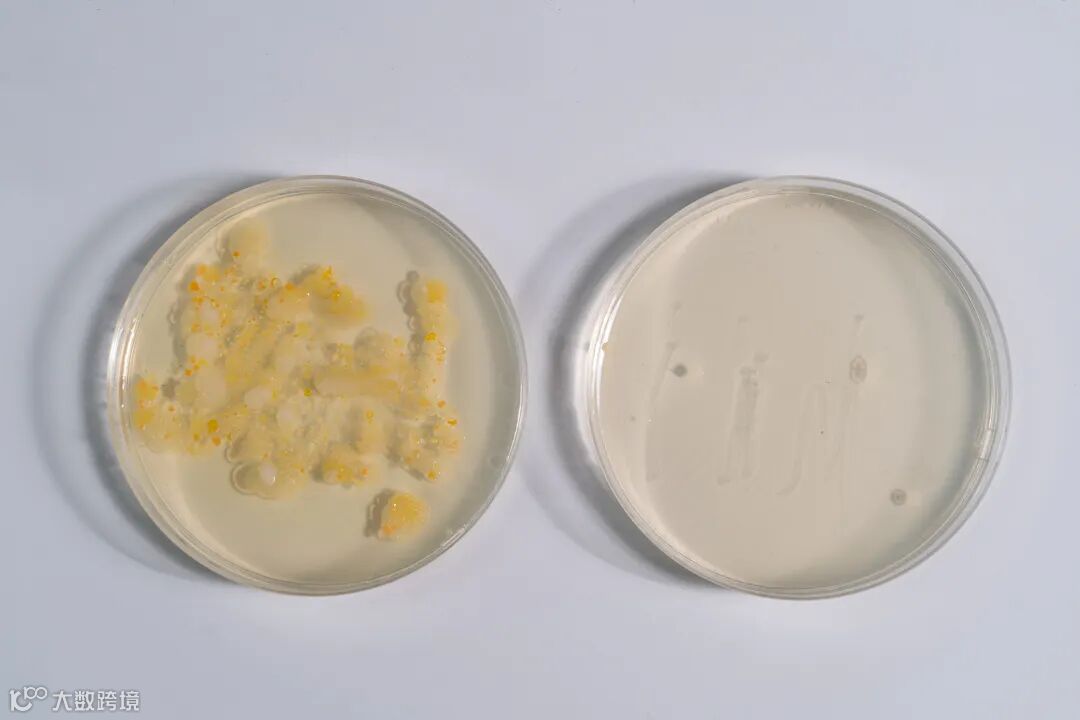

如果电器行业有个内卷排名,那么榜首一定是洗地机。
这两年洗地机发展飞快,京东筛选显示,卖洗地机的品牌已经有500个。

图源网络▲
品牌多,竞争也大,洗地机已经从单一功能,卷到吸、拖、洗一体,烘干除菌都是必备项。
行业虽然卷,但还是没碰到“天花板”。甚至卷错了方向:除了品牌不同,功能、外形都极其雷同。
再者,洗地机的清洁范围有限,只能清洁地面,全屋清洁还是需要多种工具配合。

图源网络▲
那...有没有一台既能洗地,还能“洗”全屋的机器呢?
我们还真从500个品牌、上千个型号中,找到了一台超脱洗地机局限的「机皇」—追觅M13洗地机。

和普通洗地机相比,它有:
强悍的清洁力:
98000转/分钟高速马达支撑起强劲的吸力,不管干湿垃圾,都能暴风吸入;
双系统带来双倍清洁力,双系统由双滚刷、双水路、双风道、双电机构成,一台洗地机体验双倍清洁力;
双贴边让清洁无死角,机器两侧都能靠墙无缝贴边,全屋地面清洁、一处不漏。
全面的自清洁力:
8重自清洁,全程无需人参与,就能还你一个如同全新的洗地机。
细致的体验感:
高水电配置、操作智能,用它拖地可以说是一种享受~
和洗地机整个品类相比:
它跳出了洗地机的桎梏,不只是洗地机、更是吸尘器、除螨仪。

全屋边角、从上到下,全屋立体清洁无死角。
实际使用半个月后,我愿称它为洗地机中的“机皇”,体验感满分!

推荐理由:
1、双滚刷双活水系统,两个滚刷同等高配,拖地效率翻倍,拒绝重复,1遍搞定深度脏污。
2、1秒切换多种形态,洗地机里的变形金刚,全屋立体清洁。
3、双贴边设计,全面清扫,绝不放过犄角旮旯!
4、防卡绕设计,滚刷可以双向转,让头发和滚刷说拜拜~
“两把刷子”更高效
清洁多快好省
清洁力是洗地机的重点。
理想中洗地机清洁是这样的,一推到底就能拖干净。

但现实是,一块脏污还是要像拖把一样,来回拖三四遍。

所以洗地机的问题不在清洁的不干净,而在于怎么能「更快更高效清洁」。
就像小时候赶作业,为了高效,用胶带把两支笔缠在一起写。

图源网络,小孩子请勿模仿!!!▲
先不管作业写的好坏,至少效率提高一倍,更快写完。
追觅M13的双滚刷设计就像这个捆在一起的笔尖,效率要比普通单滚刷更快、拖得更干净!

和市面上只是多加了一块布的双滚刷不同 ,追觅M13有两套活水系统。
就像两支笔有各自的管道流出墨水,机器的两个滚刷也有单独的电机、淋喷系统、脏污吸口、出风道。

简单来说,就是每个滚刷都能独立完成出水、洗地、吸进脏污,一整套清洁过程。相当于把两台洗地机缠在一起。
这样的双系统设计给了追觅M13双倍的清洁效果,再加上98000转/分钟高速马达暴风吸入,追觅M13的清洁力逆天!
原理晦涩,我们设计了极端实验,简单粗暴的展示清洁力。
01
挑战难以清洁的五类粘稠物
一些鸡蛋泡面的实验虽然看着过瘾,但并不能很好的展现清洁力。
我们选取了5种非常难拖的黏稠物。
用高温枪融化掉的巧克力、蜂巢蜜;刚熬出锅的牛油火锅锅底、芝麻糊;和小孩最爱用来乱涂乱画的颜料。

黑暗料理达成...

用刷子涂抹在白板上,用追觅M13和普通单滚刷洗地机拖过去,看拖几次能彻底拖干净。

机器走过一遍后,两台洗地机的效果差距就拉开了。

追觅M13带走了大部分的污渍,普通洗地机的残留明显。
两遍后,追觅M13拖过的白板上的黏稠物基本被清理干净。

上侧普通洗地机,下侧追觅M13洗地机▲
我们又继续用普通洗地机拖了7、8遍后,但还是有明显的蓝色刷痕。

上侧普通洗地机,下侧追觅M13洗地机▲
并且普通洗地机前后都有大量黏稠物堆积。地面上的垃圾不是被吸走,只是被推到别的地方...

左侧为追觅M13洗地机,右侧为普通洗地机▲
从玻璃板底部看,我们能获得更直观强烈的感受。
追觅的双滚刷有双倍清洁力,前滚刷没能拖干净的污渍,由后滚刷负责。
拖过的玻璃板「窗明几净」,没留下丝毫水渍、污渍,干净利索!

图中污渍从左到右为蜂蜜、粘稠的米糊、融化的巧克力▲
02
挑战「肉眼不可见」的污渍
不是所有的污渍都是可见的,比如家里的主子乱尿...
拖一遍后,基本就不会留痕迹,但地板上还会弥漫着一股淡淡的尿骚味...
这是因为在拖地时只拖掉了肉眼可见的污渍。
因为气味很难直观感受,所以我们选择了荧光剂做实验,即使只有一点点残留,在紫光灯照射下也会非常明显。

我们在地板上画出两个分区,铺上满满荧光剂,用追觅M13和普通洗地机走一遍。
一遍过后,普通洗地机一侧隐约可见一些荧光剂残留,看上去只是清洁力稍弱。

上侧普通洗地机,下侧追觅M13洗地机▲
但当我们打开紫光灯,仔细照射会发现差距非常明显!
普通洗地机这边有很多零碎的小亮块,在紫光灯下非常明显,这就是残留的荧光粉。
但追觅M13一整片紫色,毫无荧光反映。

上侧普通洗地机拖过印记,下侧追觅M13洗地机拖过印记▲
清洁力上,追觅再次胜出。
03
挑战「无菌地面」
双滚刷双系统给了追觅强大的清洁力,电解水除菌则让清洁有了质的飞跃。
洗地机自带电解水功能,不用配置,自来水就能生成除菌液,杀死99.9%的细菌。

我们在最真实的居家环境中做了实验。
用普通洗地机和追觅M13,分别在地板上拖一遍。
对左右地板取样,分别放入培养皿中,让细菌繁殖。

在室温下静置三天后,能明显看到,追觅M13拖过的地面只有零星的细菌菌落,细菌更少。
左侧为普通洗地机地面菌落,右侧为追觅M13洗地机地面菌落▲
家里有猫猫狗狗的主子,也不用担心宠物舔地板,不卫生了。
用追觅M13打扫过的地面,真正配得上「一尘不染」四个字。
全方位立体式清洁
真的能够到“天花板”
没买过洗地机的用户看详情页,大部分都会觉得洗地机全是优点,除了贵点...
但真正用下来才知道它也有很难避开的坑,比如:清洁死角。
因为要固定滚刷,大部分洗地机都会有边框,做不到贴边,或者单边固定,只能有一侧贴边。

所以拖地时会有3-5mm的清洁死角。
像厨房柜底的卡槽经常有面粉、厨余垃圾卡在边缘,用这种带边框的洗地机拖地,会全推到缝里更难清理。

屋子干干净净,只有墙根有一排脏东西,真的可以逼死强迫症!
而追觅M13改变传统思路,不用边框,改用滚轴+卡扣固定滚刷,牢固的同时做到了双贴边,地面清洁无死角。

同样的墙根卡槽,同样的垃圾,用追觅M13拖过去,一遍就能拖掉所有垃圾,毫无残留。

容易流进卡槽里的料酒、酱油也能全部拖干净。

为了效果更直观,我们特意定制了双贴边透明玻璃轨道。
在轨道上贴边倒上芝麻糊,用追觅M13拖过去,白板上的污渍一扫而空,轨道双侧的边边角角没有留下丝毫痕迹。

到这一步,追觅M13已经把地面清洁做到了极致,开始转战全屋。
目前的洗地机只融合了扫地、拖地的功能。
追觅M13在此基础上另外配备了3个刷头、融合了吸尘器和除螨仪,给清洁家电来个大乱炖。

随时变身,一台包揽更多家庭清洁。

相当于一台洗地机的价格买了洗地机+吸尘器+除螨仪。
强大吸力,家里大小尘土颗粒都能吸,只需要更换刷头,就能实现全屋清洁。

家里地面比较干净、只有浮沉、头发等轻垃圾时,换个刷头吸下尘即可。

边边角角的猫砂、掉落的食物碎屑,软毛刷边扫边吸。

沙发缝隙里的猫毛,扁口刷一吸即出。

换上尘螨刷,可以清理床褥、长毛毯上的尘螨、毛发、皮屑,直接省出一台除螨仪。

此外,向下可以清扫床底,向上可以吸顶灯上的灰尘,还有书架、柜顶、桌面、窗帘...
居家环境中,几乎所有污渍都能用这一台解决。
这才是真正“碰到天花板的”机器,真正的“机皇”!

8重自清洁,干净如新
反转设计,不缠头发
新款的洗地机基本都配备了电解水除菌、自清洁、烘干3项功能,完成自清洁。
但还存在头发卡绕在滚刷上、烘干不彻底、清洗不彻底等问题。
追觅M13在自清洁上设计了8道工序,彻底清洁整机。

01
深层除菌除污自清洁
机器自制电解水除菌,电解水会浸泡滚刷和底座,给管道、滚刷、整机深度除菌。

除菌液制备完成后,机器开始自清洁。
为了自清洁时能刮出污水,洗地机都会在滚刷附近配置刮条。
但刮条的形状决定了它只能清理滚刷表面的污渍,内部的泥垢很难被刮出。

就像用刮痧板梳头,永远梳不到里面的头发。
追觅M13把刮条换成了锯齿板,像是用篦子梳头,可以嵌入滚刷深处,把脏东西全都刮出来。

02
防卡绕自清洁
容易缠头发,也是洗地机难以避免的缺陷,很多用户在吐槽。
因为大多数的滚刷在自清洁过程中都是朝着同一个方向旋转,清洁过程中卷到滚刷上的头发会越缠越紧。

只能强忍着恶心手动拆除...

追觅M13创新设计出,正反双转的滚刷,滚刷自清洁时,在向内旋转一段时间后,会反方向旋转。

缠绕的头发会在反转时被收集到一处,吸入风口。
为了展示效果,我们先在滚刷上缠上大量头发并捏紧。

再启动滚刷自清洁功能,可以看到头发在滚刷反转的一瞬间拢成一团,被暴风吸走。

取下顶盖再看,滚刷上没有缠上去一根头发!

03
热风烘干自清洁
一些洗地机的烘干是靠甩,烘干费时费力就算了,滚刷不能完全干透,湿漉漉的很容易发霉、有异味。
追觅M13采用的是离心甩干+热风烘干。
用热成像仪实测滚刷烘干时机器的温度,滚刷处颜色明显更亮,温度比周边都要高,滚刷底部的温度达到了小50℃。

烘干结束后的滚刷还带着余温,刷毛都是柔软蓬松的,有种在太阳下烘晒了4个小时的手感~

用纸巾在滚刷表面用力按压,纸巾都还是干的,烘干一步到位。

大水电容量+智能操作
轻松搞定200平大house!
为了减轻重量,洗地机的电池、水箱容量一般都比较小,能够满足轻量打扫卫生的需求,小户型、污渍少的家庭,可以一次性打扫干净。
但对于比较大的户型,或者有宠有娃,污渍多的家庭,使用小容量的洗地机,中间需要添净水、倒污水、充电...
追觅M13洗地机做到了软硬件全能:
硬件上,900ml清水箱+700ml污水箱+5000mAh电池,这套配置和市面上的洗地机对比都算得上大的。

两个水箱拿在手里,感觉像是抱了两个大水桶...

左侧为追觅M13污水箱,右侧为追觅M13清水箱▲
软件上,智能检测地面脏污算法,可以自动调节吸力大小和出水量,做到重污重洗、轻污轻洗。
虽然所有商家都在强调自家洗地机有这项功能,但很难感受到,而追觅可以直观看到。
追觅M13会根据污渍轻重程度,在显示屏上显示出红黄绿三种颜色的光圈,隐性功能也能看得见。
在拖酱油、酸奶、麦片的混合黏稠物时,机器自动切换重污模式,屏幕光圈直接变成红色!

在拖比较稀薄、好拖的饮料时,光圈始终保持绿色。

以100平两室两厅的房间为例,实际测试下,拖完全屋,追觅M13需要耗费多少电量。

整个房子打扫下来,还有88%的电。

清水箱还有五分之四的清水,即便是200平的超大房间,一次性也能清扫干净。

高性能让机器强大,简单好用的操作给生活温度。追觅M13不仅功能强大,操作还很贴心。
超大号的LED显示屏,照顾到老年人的使用感受;按键就能切换挡位,同时还有语音播报,操作简单易懂,买给家里的老人也能一秒学会。

滚刷双向助力,向前、向后、拐弯、旋转都极其顺滑。

甚至只用一根手指头,就能控制洗地机前后移动,比起只能向前推、拉不回来的洗地机,操作更灵活、省力。

拆卸滚刷一按即可,不脏手也能拆卸滚刷。

考虑到了生活中的每个小细节~
洗地机行业“新锐”
低调的产品,高调的销量
买洗地机要相信群众的眼睛是雪亮的,毕竟是大型电器,买的人越多,说明产品越经得住用户的考验。
在今年的618大促中,开始后仅48分钟,追觅的销售额就已经破亿,同比增长700%!
在抖音扫地机直播间,1分钟登顶全站带货榜top1,洗地机直播间,1分钟登顶全站带货榜top2。

这些都是用户用钱堆出来的荣誉,比一些可有可无的奖项更真材实料,能看出追觅品牌的可信力。
在各大博主的开箱测评中,也是一水的好评,堪称“机皇”!

图源网络▲
如果有需要想选购一台洗地机,体验一把洗地机的快乐,这个追觅M13洗地机是最合适的选择。
追觅M13是刚发布不久的新品。原价6499元的机器,京东新品活动20元预售,到手4999元!
旗舰店还有更多福利!
4999元就能获得高端洗地机+吸尘器+除螨仪,买台洗地机还能省了吸尘器、除螨仪的钱。
性价比逆天!
这波冲了,绝对不亏!



